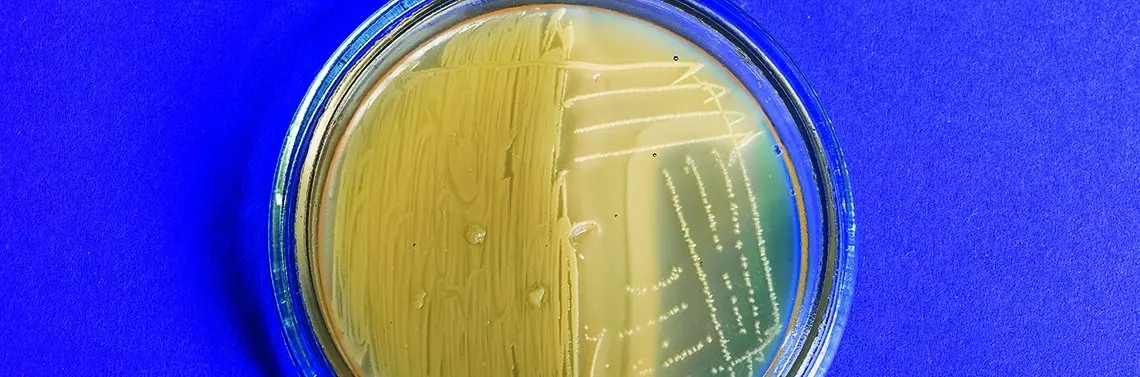

Czynniki wpływające na nawrotowość aft i ich złożone podłoże
Obecnie nie jest do końca jasne, czy afty nawrotowe powinno kwalifikować się jako schorzenie per se, czy raczej jako element składowy szerokiego spektrum objawów choroby ogólnoustrojowej [1]. Wiele badań przeprowadzonych w ostatnich latach wskazuje na częste współwystępowanie aft z przewlekłymi chorobami o podłożu zapalnym [2–4]. Nie ulega natomiast już żadnej wątpliwości, że podatność na pojawianie się wykwitów aftowych może mieć najrozmaitsze podłoże [5], a za krytyczną uważa się kombinację pewnych cech endogennych związanych z mikrośrodowiskiem samej śluzówki (m.in. profil cytokinowy i mikrobiotyczny), predyspozycji genetycznych (występowanie chociażby polimorfizmów genów cytokinowych TNF-α, IL-1β istotnie zwiększa ryzyko rozwoju aft nawrotowych [6]) i rozregulowania głównych ramion polaryzacji immunologicznej. Co również istotne, u pacjentów w okresie nawrotu choroby – w porównaniu z pacjentami w okresie remisji i zdrowych osób – obserwuje się istotnie zredukowany poziom podstawowych enzymów antyoksydacyjnych w surowicy jak dysmutaza ponadtlenkowa, katalaza czy peroksydaza glutationowa [10]. Z kolei w badaniu Lewkowicz i wsp. wartość całkowitej pojemności antyoksydacyjnej osocza u pacjentów z aftami nawrotowymi była obniżona zarówno w fazie ostrej choroby, jak i fazie remisji [11].
POLECAMY
Do czynników szczególnie modyfikujących przebieg choroby zalicza się ponadto obecność przewlekłych infekcji (m.in. Herpes simplex virus, Varicella zoster virus i Cytomegalovirus) [9], niedobory podstawowych składników mineralnych i witamin (chromu, selenu, miedzi, cynku, magnezu, żelaza, witaminy D3 i witamin z grupy B) mających bezpośredni wpływ na status antyoksydacyjny i immunologiczny pacjenta, zaburzenia gospodarki hormonalnej, nadwrażliwości pokarmowe oraz ekspozycję na silne stresory, również te występujące w żywności i środkach do higieny jamy ustnej. W badaniu Herlofsona i wsp. zastosowanie u pacjentów z nawracającymi aftami pasty do zębów bez dodatku Sodium Lauryl Sulfate (wciąż, niestety, jednego z najczęściej wykorzystywanych przez producentów detergentów w pastach i płukankach) w ciągu 3 miesięcy ponad 3,5-krotnie zredukowało częstotliwość nawrotów choroby [7]. Co więcej, w innym badaniu stosowanie tylko przez 4 dni pasty z tą substancją – w porównaniu z grupą kontrolną – gwałtownie wzmagało złuszczanie nabłonka u większości badanych osób [8].
Rozregulowanie funkcji układu immunologicznego jako kluczowy patomechanizm w powstawaniu aft nawrotowych
Pomimo wielu dotąd jeszcze niepoznanych aspektów etiologicznych aft nawrotowych to właśnie rozregulowanie funkcji układu immunologicznego – niezależne od fazy procesu chorobowego – tym większe, im cięższy jest przebieg choroby, uważane jest na chwilę obecną za jeden z najważniejszych patomechanizmów powstawania wykwitów i główny punkt odniesienia do poszukiwania skutecznych strategii terapeutycznych i zapobiegawczych. Opisywane nieprawidłowości u chorych obserwuje się na każdym etapie odpowiedzi immunologicznej. Co więcej, wielu badaczy w ostatnich latach podkreśla autoimmunizacyjny charakter immunopatomechanizmu powstawania aft nawrotowych [12–16]. Koncept ten zakłada między innymi, że nadmierna eskalacja ramienia Th1 u chorych – zarówno w okresie rzutu, jak i remisji – promuje środowisko cytokinowe korzystne dla proliferacji autoreaktywnych komórek immunokompetentnych i sprzyja tym samym rozwojowi autoimmunizacji. Istnieją również publikacje dokumentujące u pacjentów z nawrotowymi aftami obecność autoprzeciwciał przeciwko komórkom nabłonka [17], przeciwko komórkom śródbłonka [18], a nawet przeciwko komórkom mięśni gładkich [19], których nie wykryto u zdrowych badanych. W badaniach Lewkowicz i wsp. także obserwowano u pacjentów z nawracającymi aftami podwyższone miano przeciwciał przeciwko desmosomom śluzówki jamy ustnej (tych samych, które wykrywa się u osób chorujących na pęcherzycę), choć w tym przypadku nie wyklucza się wtórnego charakteru autoimmunizacji [20].
Profil wydzielanych cytokin, czyli najważniejsza determinanta kierunku polaryzacji głównych ramion immunologicznych, również wykazuje liczne nieprawidłowości u pacjentów z nawrotowymi aftami. W pracy Buño i wsp. obserwowano zwiększone stężenia podstawowych cytokin prozapalnych: interleukiny 2 (IL-2), interferonu γ (IFN-γ) i czynnika martwicy nowotworów α (ang. tumour necrosis factor α – TNF-α) w wycinkach niezmienionej śluzówki u chorych w stosunku do osób zdrowych [13]. W badaniach Lewkowicz i wsp. [21] również wykazano kilkukrotnie większe wytwarzanie wspomnianych wcześniej cytokin przez komórki jednojądrzaste krwi obwodowej pacjentów z nawrotowymi aftami oraz dwukrotnie mniejszą ilość cytokin o działaniu immunoregulacyjnym (IL-10 i transformujący czynnik wzrostu β – TGF-β) niezależnie od fazy choroby w porównaniu ze zdrowymi badanymi. Warto przy tym wspomnieć, że taki profil wydzielanych cytokin jest charakterystyczną cechą choroby autoimmunizacyjnej zależnej od limfocytów Th1, który przekłada się również na liczne zaburzenia już na wczesnym etapie aktywacji układu immunologicznego, czyli odpowiedzi wrodzonej.
Rola mikrobioty jamy ustnej w etiopatogenezie aft nawrotowych
W innej pracy Lewkowicz i wsp. [11] poświęconej właśnie aktywności neutrofilów krwi obwodowej u pacjentów z aftami nawrotowymi (jako podstawowym parametrze funkcji odporności wrodzonej, odpowiedzi przeciwdrobnoustrojowej i w stosunku do autoantygenów) dowiedziono, że są one w stanie przewlekłej preaktywacji. U pacjentów z nawrotowymi aftami stwierdza się ponadto – niezależnie od fazy choroby – istotnie wyższe poziomy składowych układu dopełniacza C3 i C4, miano całkowitego poziomu przeciwciał IgE, IgG, IgA oraz zwiększony procent limfocytów CD8+, komórek NK i zmniejszony stosunek CD4+/CD8+ niż u osób zdrowych [22].
Mimo że liczba publikacji w literaturze podmiotu jednoznacznie wskazujących na liczne nieprawidłowości w statusie immunologicznym pacjentów z aftami nadal systematycznie rośnie, znajomość lokalnych wyzwalaczy tych zaburzeń – z punktu widzenia dynamicznie zmieniającego się środowiska jamy ustnej nadzwyczaj ważna – była jeszcze do niedawna dość ograniczona. Jednak biorąc pod uwagę najnowsze doniesienia o fundamentalnej roli fizjologicznej mikrobioty w prawidłowym kształtowaniu się tkanki limfatycznej związanej z błonami śluzowymi MALT (ang. mucosa-associated lymphoid tissue) [23], a także o wielokierunkowych, niezwykle skomplikowanych ścieżkach sygnalizacyjnych, za pomocą których oddziałuje ona na lokalną i systemową odpowiedź immunologiczną, obszar ten ma szansę w niedalekiej przyszłości stać się głównym punktem wyjścia przede wszystkim do skuteczniejszego zapobiegania nawrotom choroby u pacjentów z aftami. Tym bardziej że stale obserwuje się u nich liczne zaburzenia jakościowe, ilościowe i funkcjonalne mikrobioty śluzówkowej zarówno w fazie aktywnej, jak i w fazie remisji choroby [25, 26].
Okazuje się bowiem, że mogą one w sposób istotny wspierać promowanie niekorzystnego środowiska cytokinowego śluzówki jamy ustnej i tym samym nasilać istniejące już nieprawidłowości w tym obszarze, zwłaszcza u osób predysponowanych w kierunku określonego profilu wydzielanych cytokin [6, 24]. Co więcej, wyniki aktualnych badań nad rolą czynnika bakteryjnego w rozwoju wykwitów aftowych przy użyciu nowoczesnych technik biologii molekularnej, takich jak chociażby sekwencjonowanie fragmentu 16 S rRNA, jednoznacznie wskazują na udział całościowych zaburzeń mikrobiologicznych błon śluzowych jamy ustnej w etiopatogenezie choroby, a nie pojedynczych drobnoustrojów, jak dotychczas sugerowano. Wyniki oceny składu ekosystemu bakteryjnego błony śluzowej jamy ustnej u pacjentów z nawrotowymi aftami oraz osób zdrowych przeprowadzonej przez Hijazi i wsp. [26] wykazały znaczące różnice nie tylko pomiędzy materiałami pobranymi z aktywnych zmian od pacjentów z aftami, ale również ze zdrowych miejsc w porównaniu z osobami z grupy kontrolnej. U zdrowych osób obserwowano znamiennie więcej bakterii z rodziny Streptococcaceae, stanowiących w fizjologicznych warunkach dominującą część mikrobioty jamy ustnej, natomiast u pacjentów zarówno w miejscach zmienionych chorobowo, jak i zdrowych izolowano zdecydowanie więcej bakterii z rodzin Porphyromonadaceae i Veillonellaceae.
Z kolei w pracy Kim i wsp. opublikowanej w 2016 r. na łamach „BMC Microbiology” [27] scharakteryzowano profil mikrobioty błony śluzowej jamy ustnej i śliny u pacjentów z nawrotowymi aftami i osób zdrowych nie tylko na poziomie gatunku, ale dodatkowo wskazano również dwa konkretne gatunki drobnoustrojów, które w istotny sposób mogą zwiększać ryzyko pojawienia się wykwitów. W próbkach pobranych od osób z grupy badanej – w porównaniu ze zdrowymi osobami – izolowano znacznie mniej drobnoustrojów stanowiących dominującą grupę fizjologicznego profilu mikrobioty tego obszaru, takich jak Streptococcus salivarius, Streptococcus parasanguinis, Streptococcus vestibularis, Streptococcus lactarius, Streptococcus peroris, Veillonella dispar i Prevotella histicola, natomiast zdecydowanie więcej rzadko występujących gatunków, jak chociażby Ruminococcus gnavus, Acinetobacter johnsonii, Capnocytophaga sputigena czy Neisseria oralis. Ponadto, oceniając profil mikrobiotyczny próbek śliny u osób z grupy badanej, redukcja Streptococcus salivarius i wzrost Capnocytophaga sputigena – drobnoustroju uważanego za oportunistyczny patogen zaangażowany w szerokie spektrum infekcji – były cechą charakterystyczną dla obserwowanych wykwitów na śluzówce.
Podsumowanie
Warto przy tym podkreślić, że bakterie z rodzaju Streptococcus stanowiły blisko połowę mikrobioty śluzówkowej w grupie osób zdrowych, a co najistotniejsze, w pracy Said i wsp. ich fizjologiczna kolonizacja ujemnie korelowała z mianem poziomu cytokin prozapalnych IL-1β i IL-8 w ślinie badanych [24]. Z kolei Acinetobacter johnsonii, którego populacja była jedną z dominujących u pacjentów z nawracającymi aftami, w przeciwieństwie do Streptococcus salivarius wykazywał w badaniach in vitro wzmożoną cytotoksyczność wobec komórek nabłonka i znacznie hamował ich proliferację. W podsumowaniu na podstawie analizy regresji logistycznej stwierdzono, że wzrost populacji Acinetobacter johnsonii związany jest ze znacznie zwiększonym ryzykiem rozwoju wykwitów aftowych (OR 2,11), a spadek liczebności Streptococcus salivarius zmniejsza ryzyko rozwoju choroby (OR 0,73).
Wyniki powyższych badań są niezwykle obiecujące, tym bardziej że już teraz obecne są na polskim rynku preparaty probiotyczne zawierające ściśle sklasyfikowane szczepy drobnoustrojów z gatunku Streptococcus salivarius, dedykowane pacjentom cierpiącym na nawracające infekcje górnych dróg oddechowych. Być może już wkrótce idea bakterioterapii okaże się również nieocenianym wsparciem w podtrzymywaniu remisji właśnie u pacjentów cierpiących na nawracające afty.
Piśmiennictwo:
- Baccaglini L., Lalla R.V., Bruce A.J., Sartori-Valinotti J.C., Latortue M.C., Carrozzo M., Rogers R.S. 3rd. Urban legends: recurrent aphthous stomatitis. Oral Dis 2011; 17: 755–770.
- Górska R. Diagnostyka i leczenie chorób błony śluzowej jamy ustnej. Med Tour Press International, Warszawa 2011.
- Scully C., Gorsky M., Lozada-Nur F. The diagnosis and management of recurrent aphthous stomatitis. A consensus approach. J Am Dent Assoc 2003; 134: 200–207.
- Preeti L., Magesh K., Rajkumar K., Karthik R. Recurrent aphthous stomatitis. J Oral Maxillofac Pathol 2011; 15: 252–256.
- Sosnowska-Klocek E., Feleszko W., Ziętek M. Etiologia aft przewlekłych nawracających w świetle dotychczasowych badań. Mag Stomatol 2004; 14: 107–110.
- Slebioda Z., Szponar E., Kowalska A. Recurrent aphthous stomatitis: genetic aspects of etiology. Postep Derm Alergol 2013; 30: 96‑102.
- Herlofson B.B., Barkvoll P. Sodium lauryl sulfate and recurrent aphthous ulcers. A preliminary study. Acta Odontol Scand 1994; 52: 257–259.
- Bente B. A preliminary study: Desquamative effect of sodium lauryl sulfate on oral mucosa. Department of Oral Surgery and Oral Medicine 2009
- Tarakji B., Baroudi K., Kharma Y. The effect of dietary habits on the development of the recurrent aphtous stomatitis. Niger Med J 2012; 53: 9–11.
- Zhang Z., Li S., Fang H. Enzymatic antioxidants status in patients with recurrent aphthous stomatitis. J Oral Pathol Med 2017; 46: 817–820.
- Lewkowicz N., Kurnatowska A., Lewkowicz P., Banasik M., Tchórzewski H. Rola neutrofili krwi obwodowej w patogenezie aft nawrotowych. Dent Med Probl 2002; 39: 69–77.
- Eversole L.R. Immunopathogenesis of oral lichen planus and recurrent aphthous stomatitis. Semin Cutan Med Surg 1997; 16: 284–294.
- Buño I.J., Huff J.C., Weston W.L., Cook D.T., Brice S.L. Elevated levels of interferon gamma, tumor necrosis factor alpha, interleukins 2, 4, and 5, but not interleukin 10, are present in recurrent aphthous stomatitis. Arch Dermatol 1998; 134: 827–831.
- Hasan A., Childerstone A., Pervin K., Shinnick T., Mizushima Y., Van der Zee R., Vaughan R., Lehner T. Recognition of a unique peptide epitope of the mycobacterial and human heat shock protein 65–60 antigen by T cells of patients with recurrent oral ulcers. Clin Exp Immunol 1995; 99: 392–397.
- Hasan A., Shinnick T., Mizushima Y., van der Zee R., Lehner T. Defining a T−cell epitope within HSP65 in recurrent aphthous stomatitis. Clin Exp Immunol 2002; 128: 318–325.
- Sun A., Chia J.S., Chiang C.P. Increased proliferative response of peripheral blood mononuclear cells and T cells to Streptococcus mutans and glucosylotransferase D antigens in the exacerbation stage of recurrent aphthous ulcerations. J Formos Med Assoc 2002; 101: 560–566.
- Sun A., Hsieh R.P., Liu B.Y., Wang J.T., Leu J.S., Wu Y.C., Chiang C.P. Strong association of antiepithelial cell antibodies with HLA−DR3 or DR7 phenotype in patients recurrent oral ulcers. J Formos Med Assoc 2000; 99: 290–294.
- Healy C.M., Carvalho D., Pearson J.D., Thornhill M.H. Raised anti−endothelial cell autoantibodies, but not anti−neutrophil cytoplasmic autoantibodies, in recurrent oral ulceration: modulation of AECA binding by tumour necrosis factor−alpha and interferon−gamma. Clin Exp Immunol 1996; 106: 523–528.
- Sun A., Wu Y.C., Wang J.T., Liu B.Y., Chiang C.P. Association of HLA−te22 antigen with anti−nuclear antibodies in Chinese patients with erosive oral lichen planus. Proc Natl Sci Counc Repub China B 2000; 24: 63–69.
- Lewkowicz N., Tchórzewski H., Kurnatowska A., Lewkowicz P. Obecność autoprzeciwciał przeciw desmosomom u chorych z aftami nawracającymi. Dent Med Probl 2004; 41: 661–669.
- Lewkowicz N., Banasik A., Tchórzewski H., Kurnatowska A., Lewkowicz P. Przewaga wytwarzania cytokin typu Th1 u chorych z aftami nawracającymi. Dent Med Probl 2004; 41: 655–660.
- Ruan H.H., Li G.Y., Duan N., Jiang H.L., Fu Y.F., Song Y.F., Zhou Q., Wang X., Wang W.M. Frequencies of abnormal humoral and cellular immune component levels in peripheral blood of patients with recurrent aphthous ulceration. Journal of Dental Sciences 2018; 13: 124–130.
- Honda K., Littman D.R.The microbiota in adaptive immune homeostasis and disease. Nature 2016; 535: 75–84.
- Said H.S., Suda W., Nakagome S., Chinen H., Oshima K., Kim S., Kimura R., Iraha A., Ishida H., Fujita J., Mano S., Morita H., Dohi T., Oota H., Hattori M. Dysbiosis of salivary microbiota in inflammatory bowel disease and its association with oral immunological biomarkers. DNA Res 2014; 21: 15–25.
- Bankvall M., Sjöberg F., Gale G., Wold A., Jontell M., Östman S.The oral microbiota of patients with recurrent aphthous stomatitis. J Oral Microbiol 2014; 6: 25 739.
- Hijazi K., Lowe T., Meharg C., Berry S.H., Foley J., Hold G.L. Mucosal microbiome in patients with recurrent aphthous stomatitis. J Dent Res 2015; 94 (3 Suppl): 87S–94 S.
- Kim Y.J., Choi Y.S., Baek K.J., Yoon S.H., Park H.K., Choi Y. Mucosal and salivary microbiota associated with recurrent aphthous stomatitis. BMC Microbiol 2016; 16 Suppl 1: 57.